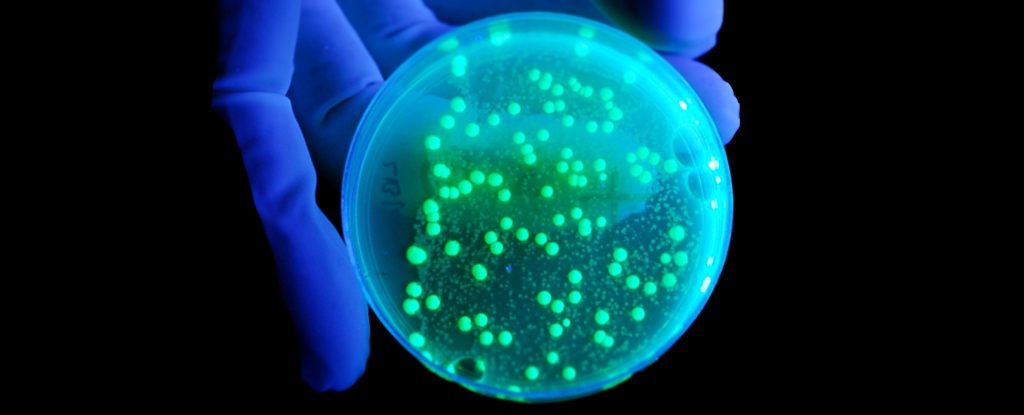
Featured image for "Disease X: The Looming Threat and Global Pandemic Preparations"

Six years after COVID-19, global pandemic preparedness shows gains but remains fragile
Six years after the WHO declared COVID-19 a Public Health Emergency of International Concern, the world has strengthened preparedness through measures like the WHO Pandemic Agreement, IHR amendments, and the Pandemic Fund, plus expanded surveillance and vaccine/biotech capacity; however, progress is uneven and fragile, underscoring the need for sustained global collaboration to prevent the next pandemic.